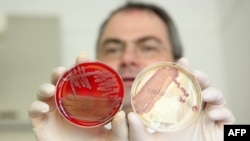
Профессор Гельмут Фикеншер: сальмонелланын бактериясы антибиотиктерди тоотпой калган, Киель, Германия, 01.06.2011.

Британиялык окумуштуулар антибиотиктерди тоотпогон бактерияны жок кылуунун жолдорун табышты. Бул тууралуу Nature журналы кабарлады. Акыркы элүү жылда айрым бактерияларга күчтүү антибиотик дарылардын алы жетпей калган. Бул бактериялар сальмонелла, пневмония, диарея, менингит, гонорея жана башка илдеттерди козгойт. Мындай коркунучтуу бактериянын жети түрү бар.
Май айында Дүйнөлүк саламаттыкты сактоо уюму "пост-антибиотик" доору келип, бактериянын мындай түрлөрү чоң коркунуч жаратууда деп коңгуроо каккан. Бул уюмдун билдирүүсүнө ылайык, антибиотиктерди тоотпогон бактерия дүйнөнүн 114 өлкөсүндө – анын ичинде Кыргызстанда дагы кездешет. Бул бактериялар карбапенем өңдүү күчтүү антибиотиктерди дагы тоготпойт.
Ал эми Кыргызстанда антибиотиктин алы жетпеген бактериялар кургак учук оорусун оорлоштурган учурлар катталган. Мисалы, туберкулёзго каршы дарылоо курсунун аягына чейин ичпей, кайра антибиотиктерди ичип баштаганда, кургак учук антибиотиктерди тоотпой калган. Өлкө боюнча учурда миңге жакын бейтапта бул бактерия аныкталган.
Бактериологдор болсо муну бактериялардын мутациясы жана эволюциясы менен түшүндүрүшөт. Мунун себептеринин бири – адам канчалык көп антибиотик ичсе, анын организми ошончолук антибиотиктерди тоотпой калат. Антибиотиктерге туруштук бере алган бактериялардын коргонуу механизминде белоктун эки эсе күчөтүлгөн молекуласы бар.
Дарыгердин көрсөтмөсү жок антибиотиктерди ичүү Кыргызстанда кадыресе көрүнүш. Азыркы тапта Саламаттыкты сактоо министрлиги антибиотиктерди рецепт менен гана сатуу тууралуу буйрукту даярдап жатат. Бирок бул буйрук Кыргызстандагы 2700 дарыканада кантип ишке ашары аныктала элек.
Кыргызстанда антибиотиктерди тоотпогон бактериялардын жайылышынын себептеринин бири - дарыларды башаламан ичүү.
Саламаттыкты сактоо министрлигинин Дары-дармек департаментинин маалымат борборунун башчысы Замир Акаев төмөнкүлөргө токтолду:
– Ар бир бактерия же оору козгоочу микробдорго өзүнүн күчү жеткен антибиотик бар. Антибиотиктерди жөн эле иче берүү – текке кеткен акча жана убакыт. Биринчиден, дарыгер гана кайсыл бактерияны кайсыл антибиотик жок кылаарын билет. Антибиотиктерди аз жана туура колдонуу керек. Канчалык көп жана канчалык натуура колдонгондо, микробдору ошого көнүп калат. Биздин максатыбыз – антибиотиктерди башаламан ичүүнү жөнгө салуу. Негизи, дарылар аптекалардан рецепт менен гана сатылышы керек.
Британиядагы илимий ачылышка ылайык, жаңы препарат мындай бактериянын тышкы кабыгынын калыңдашына бөгөт коюп, аны алсыздандырат. Бул бактериялардын курамы интенсивдүү рентген нурлары аркылуу аныкталган. Nature журналы жазгандай, Чыгыш Англия университетинин профессору Чаңжиаң Доң эми антибиотиктерге туруштук бере алган бактериянын LptDE белогун жок кыла турган дарыны жасоо башталарын билдирди.
Профессор Доң окумуштуулар LptDE белогу бактериянын сырткы мембранасын кандайча кураары аныкталганын түшүндүрөт. Бактериянын сырткы катмарында кымындай жылчыкча бар. Дал ушул жылчыкча аркылуу бактериянын ичине кирип бузуу үчүн илимпоздор ал жылчыкчадан өтө ала турган кичинекей молекуланы ойлоп табышты.
Антибиотиктерди тоотпогон бактериялар барган сайын кубулуп, күчтүү антибиотиктерден коргонуу механизмдерин иштеп чыгышат. Мембранадагы липиддер бактериянын ичине эч бир дарыны киргизбейт. Окумуштуулар аты коюла элек жаңы дарынын көмөгү аркылуу мындай туруктуу бактерия менен күрөшүүнүн жолдорун табышты.
Бул изилдөө учурда баштапкы баскычта болсо дагы акыркы 10 жылда бактериологиядагы көптү үмүттөндүргөн иштердин бири катары сыпатталууда. Дүйнөлүк саламаттыкты сактоо уюмунун маалыматы боюнча, сальмонелла бактериясынан жылына 16 миллион адам жабыркап, алардын 600 миңи өлүмгө дуушар болот. Ал эми менингиттен жылына дүйнөдө 420 миң адам көз жумат.